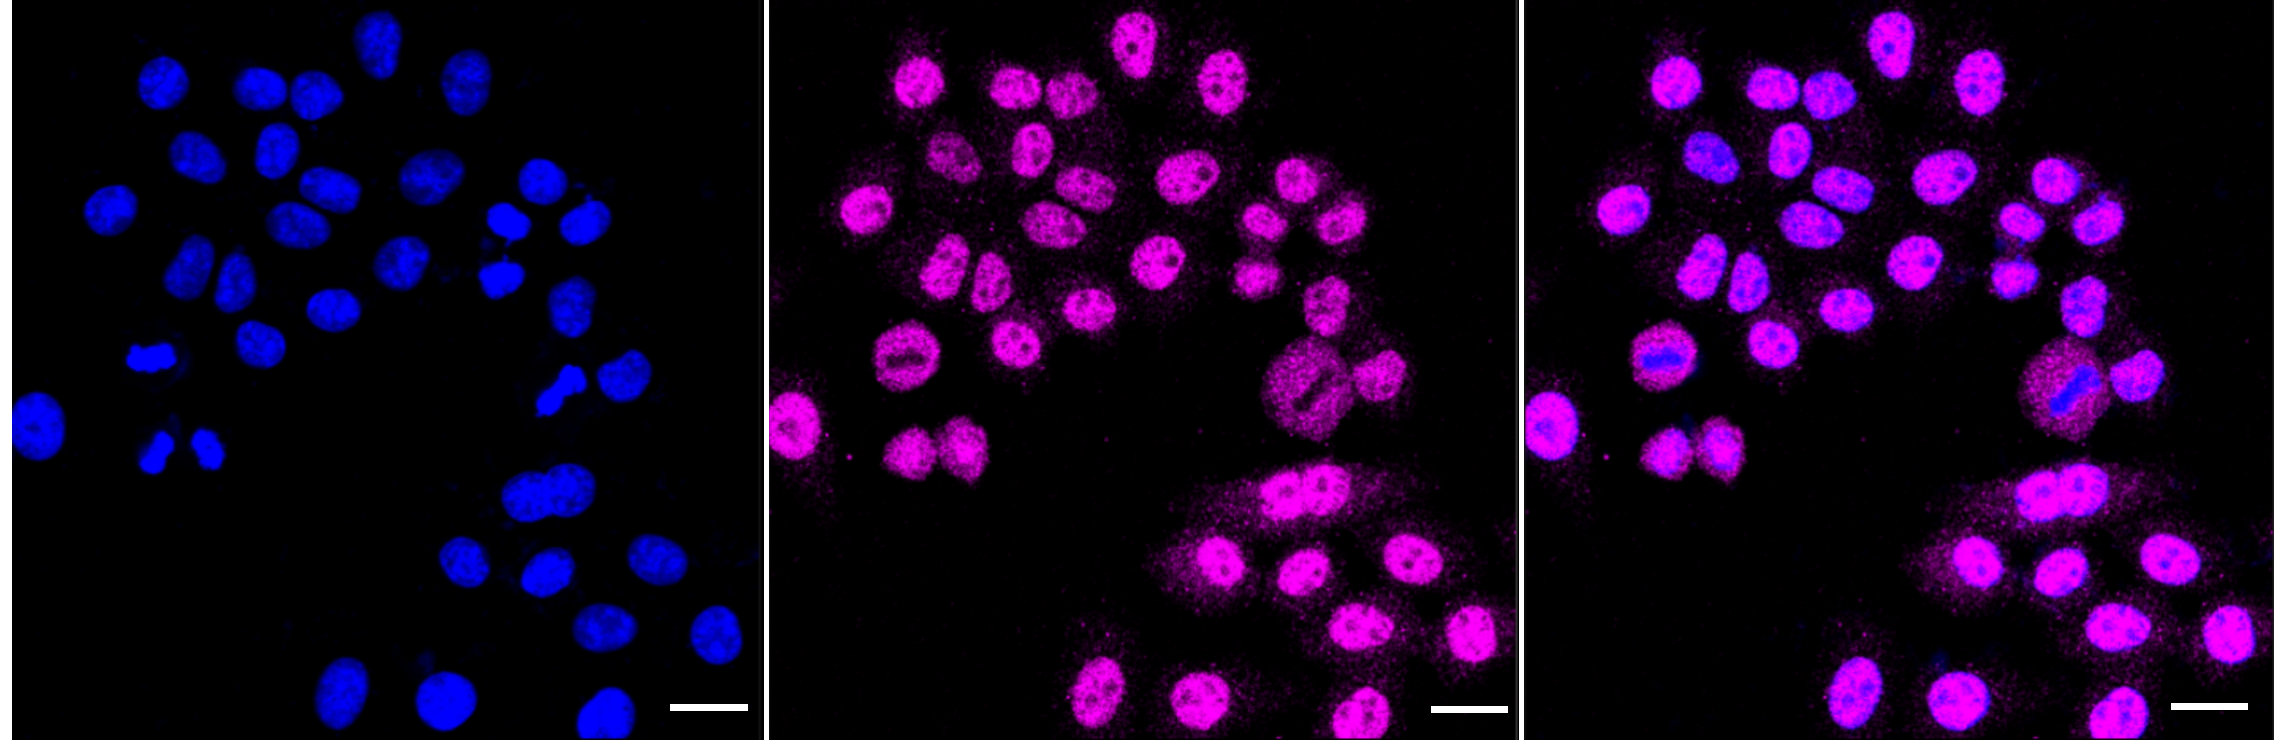

ELK1 Recombinant Monoclonal Antibody
-
中文名稱:ELK1 Recombinant Monoclonal Antibody
-
貨號:CSB-RA905149A0HU
-
規格:¥1320
-
圖片:
-
Flow cytometric analysis of ELK1 expression in HepG2 cells using ELK1 antibody. Green, isotype control; red, ELK1.
-
Immunocytochemical staining of HepG2 cells with ELK1 antibody. Nuclei were stained blue with DAPI; ELK1 was stained magenta with Alexa Fluor? 647. Images were taken using Leica stellaris 5. Protein abundance based on laser Intensity and smart gain: Medium. Scale bar: 20 μm.
-
Western blotting analysis using ELK1 antibody. Total cell lysates (30 μg) from various cell lines were loaded and separated by SDS-PAGE. The blot was incubated with ELK1 antibody and HRP-conjugated goat anti-rabbit secondary antibody respectively.
-
-
其他:
產品詳情
-
Uniprot No.:
-
基因名:
-
別名:ELK1; ETS Transcription Factor ELK1; ELK1, Member Of ETS Oncogene Family; ETS Domain-Containing Protein Elk-1; Tyrosine Kinase (ELK1) Oncogene; ELK1, ETS Transcription Factor; ETS-Like Gene 1
-
反應種屬:Human, Mouse, Rat
-
免疫原:Recombinant Human ELK1 protein
-
免疫原種屬:Homo sapiens (Human)
-
標記方式:Non-conjugated
-
克隆類型:Monoclonal
-
抗體亞型:Rabbit IgG
-
純化方式:Affinity-chromatography
-
克隆號:16B11
-
濃度:It differs from different batches. Please contact us to confirm it.
-
保存緩沖液:Rabbit IgG in PBS (pH 7.4) containing 50% glycerol, and 0.02% sodium azide.
-
產品提供形式:Liquid
-
應用范圍:ELISA, WB, FC, ICC
-
推薦稀釋比:
Application Recommended Dilution WB 1:1000-1:5000 FC 1:200-1:2000 ICC 1:100-1:1000 -
Protocols:
-
儲存條件:Upon receipt, store at -20°C or -80°C. Avoid repeated freeze.
-
貨期:Basically, we can dispatch the products out in 1-3 working days after receiving your orders. Delivery time maybe differs from different purchasing way or location, please kindly consult your local distributors for specific delivery time.
-
用途:For Research Use Only. Not for use in diagnostic or therapeutic procedures.
相關產品
靶點詳情
-
功能:Transcription factor that binds to purine-rich DNA sequences. Forms a ternary complex with SRF and the ETS and SRF motifs of the serum response element (SRE) on the promoter region of immediate early genes such as FOS and IER2. Induces target gene transcription upon JNK-signaling pathway stimulation.
-
基因功能參考文獻:
- enhanced ETS factor activity and the transcription of ETS family target genes related to spliceosome function and cell death induction via alternate MCL1 splicing, is reported. PMID: 29118074
- Authors found that miR-185-5p decreases HBV S1p activity by targeting ELK1. PMID: 30308183
- High ELK1 expression is associated with thyroid cancer progression. PMID: 30015900
- ID1, CTCF and ELK1 may be associated with prostate cancer, and may be potential therapeutic targets for the treatment of this disease. PMID: 29956775
- Study demonstrates that miR-135a regulates cell proliferation in breast cancer by targeting ELK1 and ELK3 oncogenes, and suggests that miR-135a potentially can act as a tumor suppressor. PMID: 29892795
- Phospho-ELK1 overexpression serves as a predictor of poor prognosis in patients with urothelial carcinoma of the upper urinary tract. PMID: 29518027
- TAB1 was identified as a functional target of miR-134, and the expression of TAB1 was increased by the transcription factors of NF-kappaB1, c-Rel, and ELK1 via miR-134. PMID: 28206956
- This study indicated that lncrna-TCONS_00026907 was upregulated in cervical cancer and TCONS_00026907 promoted the progression of cervical cancer through inhibition of miR-143-5p and promotion of ELK1. PMID: 28544557
- FOXE1 interacts with ELK1 on thyroid relevant gene promoters, establishing a new regulatory pathway for its role in adult thyroid function. Co-regulation of TERT suggests a mechanism by which allelic variants in/near FOXE1 are associated with thyroid cancer risk. PMID: 27852061
- Data suggest that inability of lithium, an anti-manic agent, to regulate circadian rhythms in cells from patient with bipolar disorder reflects reduced ERK1/2 activity and MAP kinase signaling through ELK1. (ERK = extracellular signal-related kinase; ELK1 = ETS-domain protein ELK1) PMID: 27216486
- we have shown that miR-1275 is a novel negative regulator of human visceral preadipocyte differentiation, which appears to act via post-transcriptional silencing of ELK1. PMID: 27154547
- Purified ELK1 and AR bound with a dissociation constant of 1.9 x 10(-8) m A purified mutant ELK1 in which the D-box and DEF motifs were disrupted did not bind AR. PMID: 27793987
- Study identified ELK1 as a novel target for miR- 150 which is up-regulated in apoptotic human umbilical cord vein endothelial cells. PMID: 28110404
- Study identified a core region encompassing nt - 118 to + 108 of IPO4 gene that is necessary for its promoter activity. Transcription factors binding to this region were screened, resulting in the identification of two members of the Ets family, Ets-like transcription factor-1 and GA binding protein, which repress or activate its promoter activity, respectively. PMID: 28254634
- High expression of ELK1 is associated with cholangiocarcinoma. PMID: 27658773
- Overexpression of PAD4 constrains the activity of EMT via suppressing Elk1 expression. PMID: 27176594
- These data reveal a novel role for Elk1 regulating ITGB6 expression and highlight how dysregulation of Elk1 can contribute to human disease. PMID: 26861876
- Downregulated expression of transcriptional activator ELK-1 may play an important role in the pathogenesis of atrial fibrillation. PMID: 26617947
- ELK1 is likely to be activated in prostate cancer cells and promote tumor progression. Furthermore, silodosin that inactivates ELK1 in prostate cancer cells not only inhibits their growth but also enhances the cytotoxic activity of gemcitabine. PMID: 26864615
- results suggest that ELK1 plays an important role in bladder tumorigenesis and cancer progression. PMID: 26342199
- Negative feedback regulation of AXL by miR-34a modulates apoptosis in lung cancer cells by activating the transcription factor ELK1 via the JNK signaling pathway. PMID: 26667302
- These findings suggest that PKCalpha expression in HCC could be stimulated by the formation of MZF-1/Elk-1 complex, which directly binds to the PKCalpha promoter. PMID: 26010542
- interleukin-1beta (IL-1beta)-induced IER3 expression is mediated by the ERK1/2 target, transcription factor Elk-1. PMID: 25066273
- Data show that afatinib reduced Elk-1 transcription factor binding to the CIP2A protein promoter and suppressed CIP2A transcription. PMID: 25537503
- TNF-alpha modulation of intestinal epithelial tight junction barrier is regulated by ERK1/2 activation of Elk-1. PMID: 24121020
- Analysis implies a role of ELK-1 in the differences between pluripotent stem cells with distinct X chromosome inactivation statuses. PMID: 23871667
- Elk-1 interacts with the cell cycle kinase Aurora-A, and when Aurora inhibitors are used, P-S383-Elk-1 fails to localize to the poles and remains associated with DNA. PMID: 23322625
- our data suggest that preferential binding of activated Elk-1 to the IL10 rs3122605-G allele upregulates IL10 expression and confers increased risk for SLE in European Americans. PMID: 24130510
- Two members of the ETS (E-26) family (PEA3 and ELK-1) regulate the expression of miRNA-200b. PEA3 promotes the expression of miRNA-200b, and ELK-1 is a transcriptional repressor of miRNA-200b. PMID: 24072701
- FBXO25 mediates ELK-1 degradation through the ubiquitin proteasome system and thereby plays a role in regulating the activation of ELK-1 pathway in response to mitogens PMID: 23940030
- The binding of Ets1 and Elk1 together to the proximal CIP2A promoter is absolutely required for CIP2A expression in cervical, endometrial and liver carcinoma cell lines PMID: 23117818
- Sorafenib induces endometrial carcinoma apoptosis by inhibiting Elk-1-dependent Mcl-1 transcription and inducing Akt/GSK3beta-dependent protein degradation. PMID: 23463670
- Authors define the minimal promoter region of EVI1 and demonstrate that RUNX1 and ELK1, two proteins with essential functions in hematopoiesis, regulate EVI1 in AML. PMID: 22689058
- Ethanol increases Pol III transcription through a response element which is composed of the overlapping Elk1 and AP-1 binding sites of the TBP promoter. The binding sites may play a role in ethanol-induced deregulation of Pol III genes in liver tumors. PMID: 23454483
- Strikingly, promoters bound by ELK1 without ERK2 are occupied by Polycomb group proteins that repress genes involved in lineage commitment. PMID: 23727019
- although ELK1 and GABPA ultimately control the same biological process, they do so by regulating different cohorts of target genes associated with cytoskeletal functions and cell migration contro PMID: 23284628
- Elk-1 pT417 is present in epithelial cell nuclei of various normal and cancer tissues and the number of pT417-positive cells correlates with differentiation grade of colonic adenocarcinomas. PMID: 23114923
- The ETS domain transcription factor ELK1 directs a critical component of growth signaling by the androgen receptor in prostate cancer cells. PMID: 23426362
- Elk1 is positively associated with estrogen receptor and Cyclin D1 expression in breast cancer. Luminal A/B Her-2 negative subtypes showed more Elk-1 activity compared to Her-2 and Basal subtype. No clinicopathologic or prognostic associations were found. PMID: 23127278
- This is demonstrated for the unique binding mode where a novel role for ELK1 in controlling cell migration is revealed. PMID: 22589737
- demonstrate that ELK-1 expression arises by a combination of leaky scanning and reinitiation, with the latter mediated by the small upstream ORF2 conserved in both spliced isoforms PMID: 22354998
- Although the findings showed elevated expression of Elk-1 and PKCalpha in 5637 cells, the regulator of PKCalpha in bladder cancer cells is yet to be determined. PMID: 22559731
- association between the expression of PKCalpha and the expression of the transcription factors Elk-1 and MZF-1 in breast cancer cell lines PMID: 22242952
- Activation of the Elk-1 led to an increased survival and a proliferative response with the EGF stimulation, and knocking-down the Elk-1 caused a decrease in survival of U138 glioblastoma cells. PMID: 22085529
- Formation of ternary complex of human biliverdin reductase-protein kinase Cdelta-ERK2 protein is essential for ERK2-mediated activation of Elk1 protein, nuclear factor-kappaB, and inducible nitric-oxidase synthase (iNOS). PMID: 22065579
- DJ-1 regulates SOD1 expression through Erk1/2-Elk1 pathway in its protective response to oxidative insult. PMID: 21796667
- the ERK/ELK-1 cascade is involved in p53-independent induction of p21 and BAX gene expression. PMID: 21642427
- Genome-wide analysis reveals PADI4 cooperates with Elk-1 to activate c-Fos expression in breast cancer cells. PMID: 21655091
- AC3-33 is a novel member of the secretory family and inhibits Elk1 transcriptional activity via ERK1/2 MAP PMID: 20680465
- preferential activation of PTPRZ1 by HIF-2 results at least in part from cooperative binding of HIF-2 and ELK1 to nearby sites on the PTPRZ1 promoter region PMID: 20224786
顯示更多
收起更多
-
亞細胞定位:Nucleus.
-
蛋白家族:ETS family
-
組織特異性:Lung and testis.
-
數據庫鏈接:
Most popular with customers
-
YWHAB Recombinant Monoclonal Antibody
Applications: ELISA, WB, IHC, IF, FC
Species Reactivity: Human, Mouse, Rat
-
Phospho-YAP1 (S127) Recombinant Monoclonal Antibody
Applications: ELISA, WB, IHC
Species Reactivity: Human
-
-
-
-
-
-